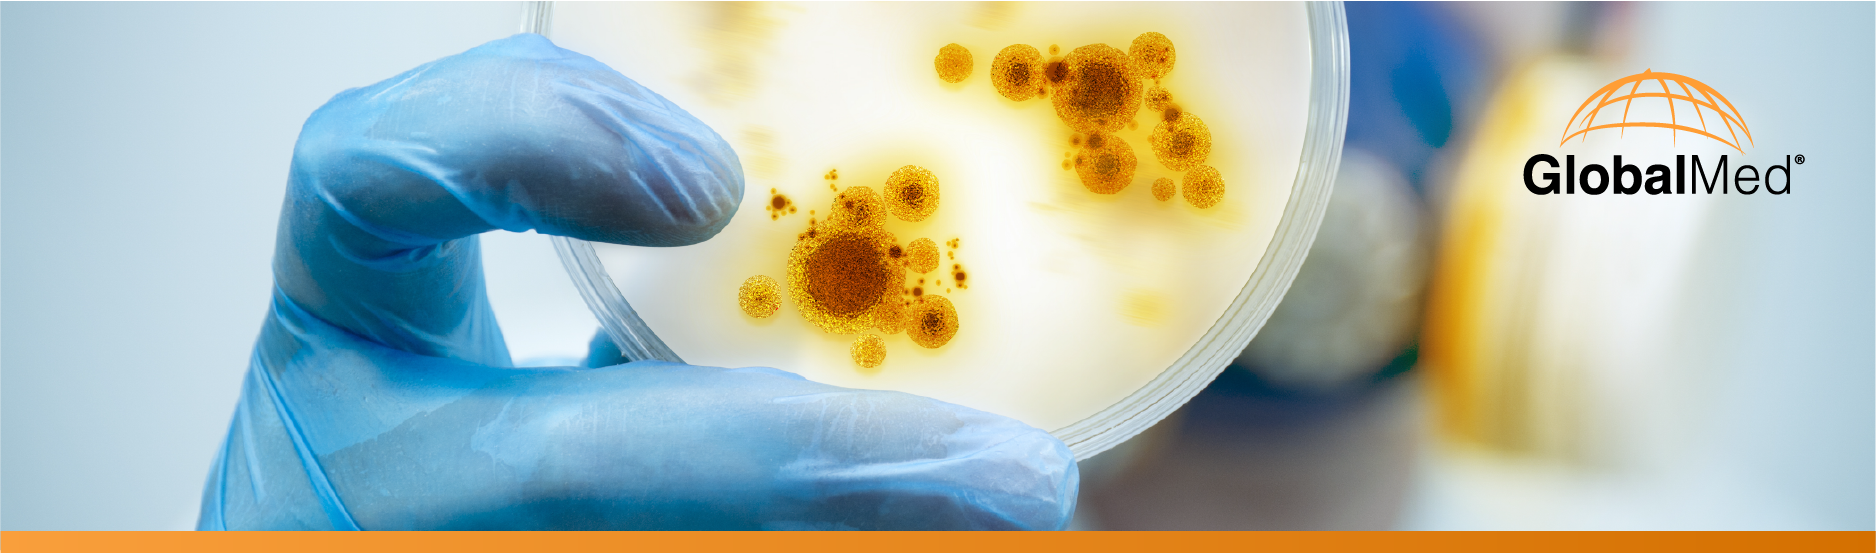

Anyone in the healthcare field knows that the demand for providers is outpacing the supply. Current estimates say the U.S. will be short 122,000 doctors by 2032. While that’s an unnerving number, what’s really worrying is the shortage of infectious and parasitic disease (ID) specialists.
ID specialists seem to be a dwindling breed. They play a critical role in curtailing the spread of outbreaks; unlike a cardiologist or obstetrician, ID specialists can stop dozens or hundreds of potential patients from getting sick by treating just one patient. But every year, infectious disease training fellowships go unfilled. According to the National Resident Matching Program, the number of programs filling available training positions dropped by more than 40 percent between 2009 and 2017. At best, a small hospital may share a full-time ID specialist with 6 or 7 other regional hospitals. Or they may not have one at all.
That’s not just inconvenient. It’s frightening. We live in an age of antibiotic-resistant microbes, also called “superbugs,” where the possibility of widespread drug resistance has global implications. Partly because of the opioid epidemic, experts are also noticing the emergence of human immunodeficiency virus (HIV) and sexually transmitted infection outbreaks well beyond metropolitan areas.
But a traditional ID practice can be tough to sustain outside of large cities. Tuberculosis, Lyme disease, meningococcal disease and salmonella don’t present a steady pipeline of patients; the demand fluctuates. This means many local providers may be unfamiliar with a new contagion sweeping into town – or the available treatment options. While time is of the essence with an infection, timely care can be hard to find.
That’s why more hospitals are turning to telemedicine to treat single infections and help control contagions – by democratizing medical expertise across large and small communities.
Losing the Fight Against Infection
When small town patients present at the local hospital with a parasitic or infectious disease, they’re often transferred to hospitals more than an hour away. The same applies to organ transplant recipients, patients with drug-resistant organisms and other medically fragile patients. These transfers cut into the small hospital’s revenue, drive up no-show rates and burden patients with high travel costs. They also increase the likelihood of delayed care and poor outcomes – and possibly a continuing spread of infection in the community.
There’s also a higher risk when providers attempt to diagnose and treat infections without specialized training. In 2018, the Food and Drug Administration approved powerful antibiotics to treat the threat of “superbugs” – drugs such as eravacycline, plazomicin and omadacycline. But many providers don’t know how to use these medicines. Nor do they always understand how to treat infections alongside other illnesses. Matt McCarthy, author of “Superbugs: The Race to Stop an Epidemic,” noted that his father-in-law nearly died when he was diagnosed with a potentially lethal bacterium, Staphylococcus aureus, while undergoing pancreatic cancer treatment. A physician initially stopped his cancer treatments to address the infection, a decision that almost killed him until he was transferred to the care of an ID specialist who was able to treat both.
Lifeline to Advanced Care
That’s just one example of why hospitals and clinics must be able to contact infectious disease experts immediately, even when none are available in their vicinity or healthcare network. By establishing a lifeline to advanced care, tele-ID can:
- Keep patients in their community, without transferring to a distant hospital
- Treat infections sooner, shorten hospital stays and reduce healthcare costs
- Limit outbreaks, by helping doctors recognize and diagnose conditions faster
- Improve medication management protocols, decreasing the risk of harmful drug reactions and antibiotic resistance
- Manage capacity in facilities that do have ID specialists, instead of becoming overwhelmed during an outbreak
- Help providers monitor discharged patients to keep tabs on their recovery
From virus outbreaks to the threat of drug-resistant organisms to government penalties for healthcare-associated infections, all providers must have immediate access to ID expertise that can help them diagnose, treat and prevent infections. The provider shortage won’t be solved anytime soon. But by extending real-time advanced care across patient populations and healthcare facilities, tele-ID can control epidemics – or stop them from happening at all.[nectar_cta btn_style=”see-through” heading_tag=”h4″ text_color=”#0033cc” button_color=”default” link_type=”new_tab” alignment=”center” alignment_tablet=”default” alignment_phone=”default” display=”block” text=”Expand access to care, reduce provider burden, lower costs, and improve outcomes with telemedicine technologies.” link_text=”Contact Us” url=”http://globalmed.com/schedule-a-demo/”]